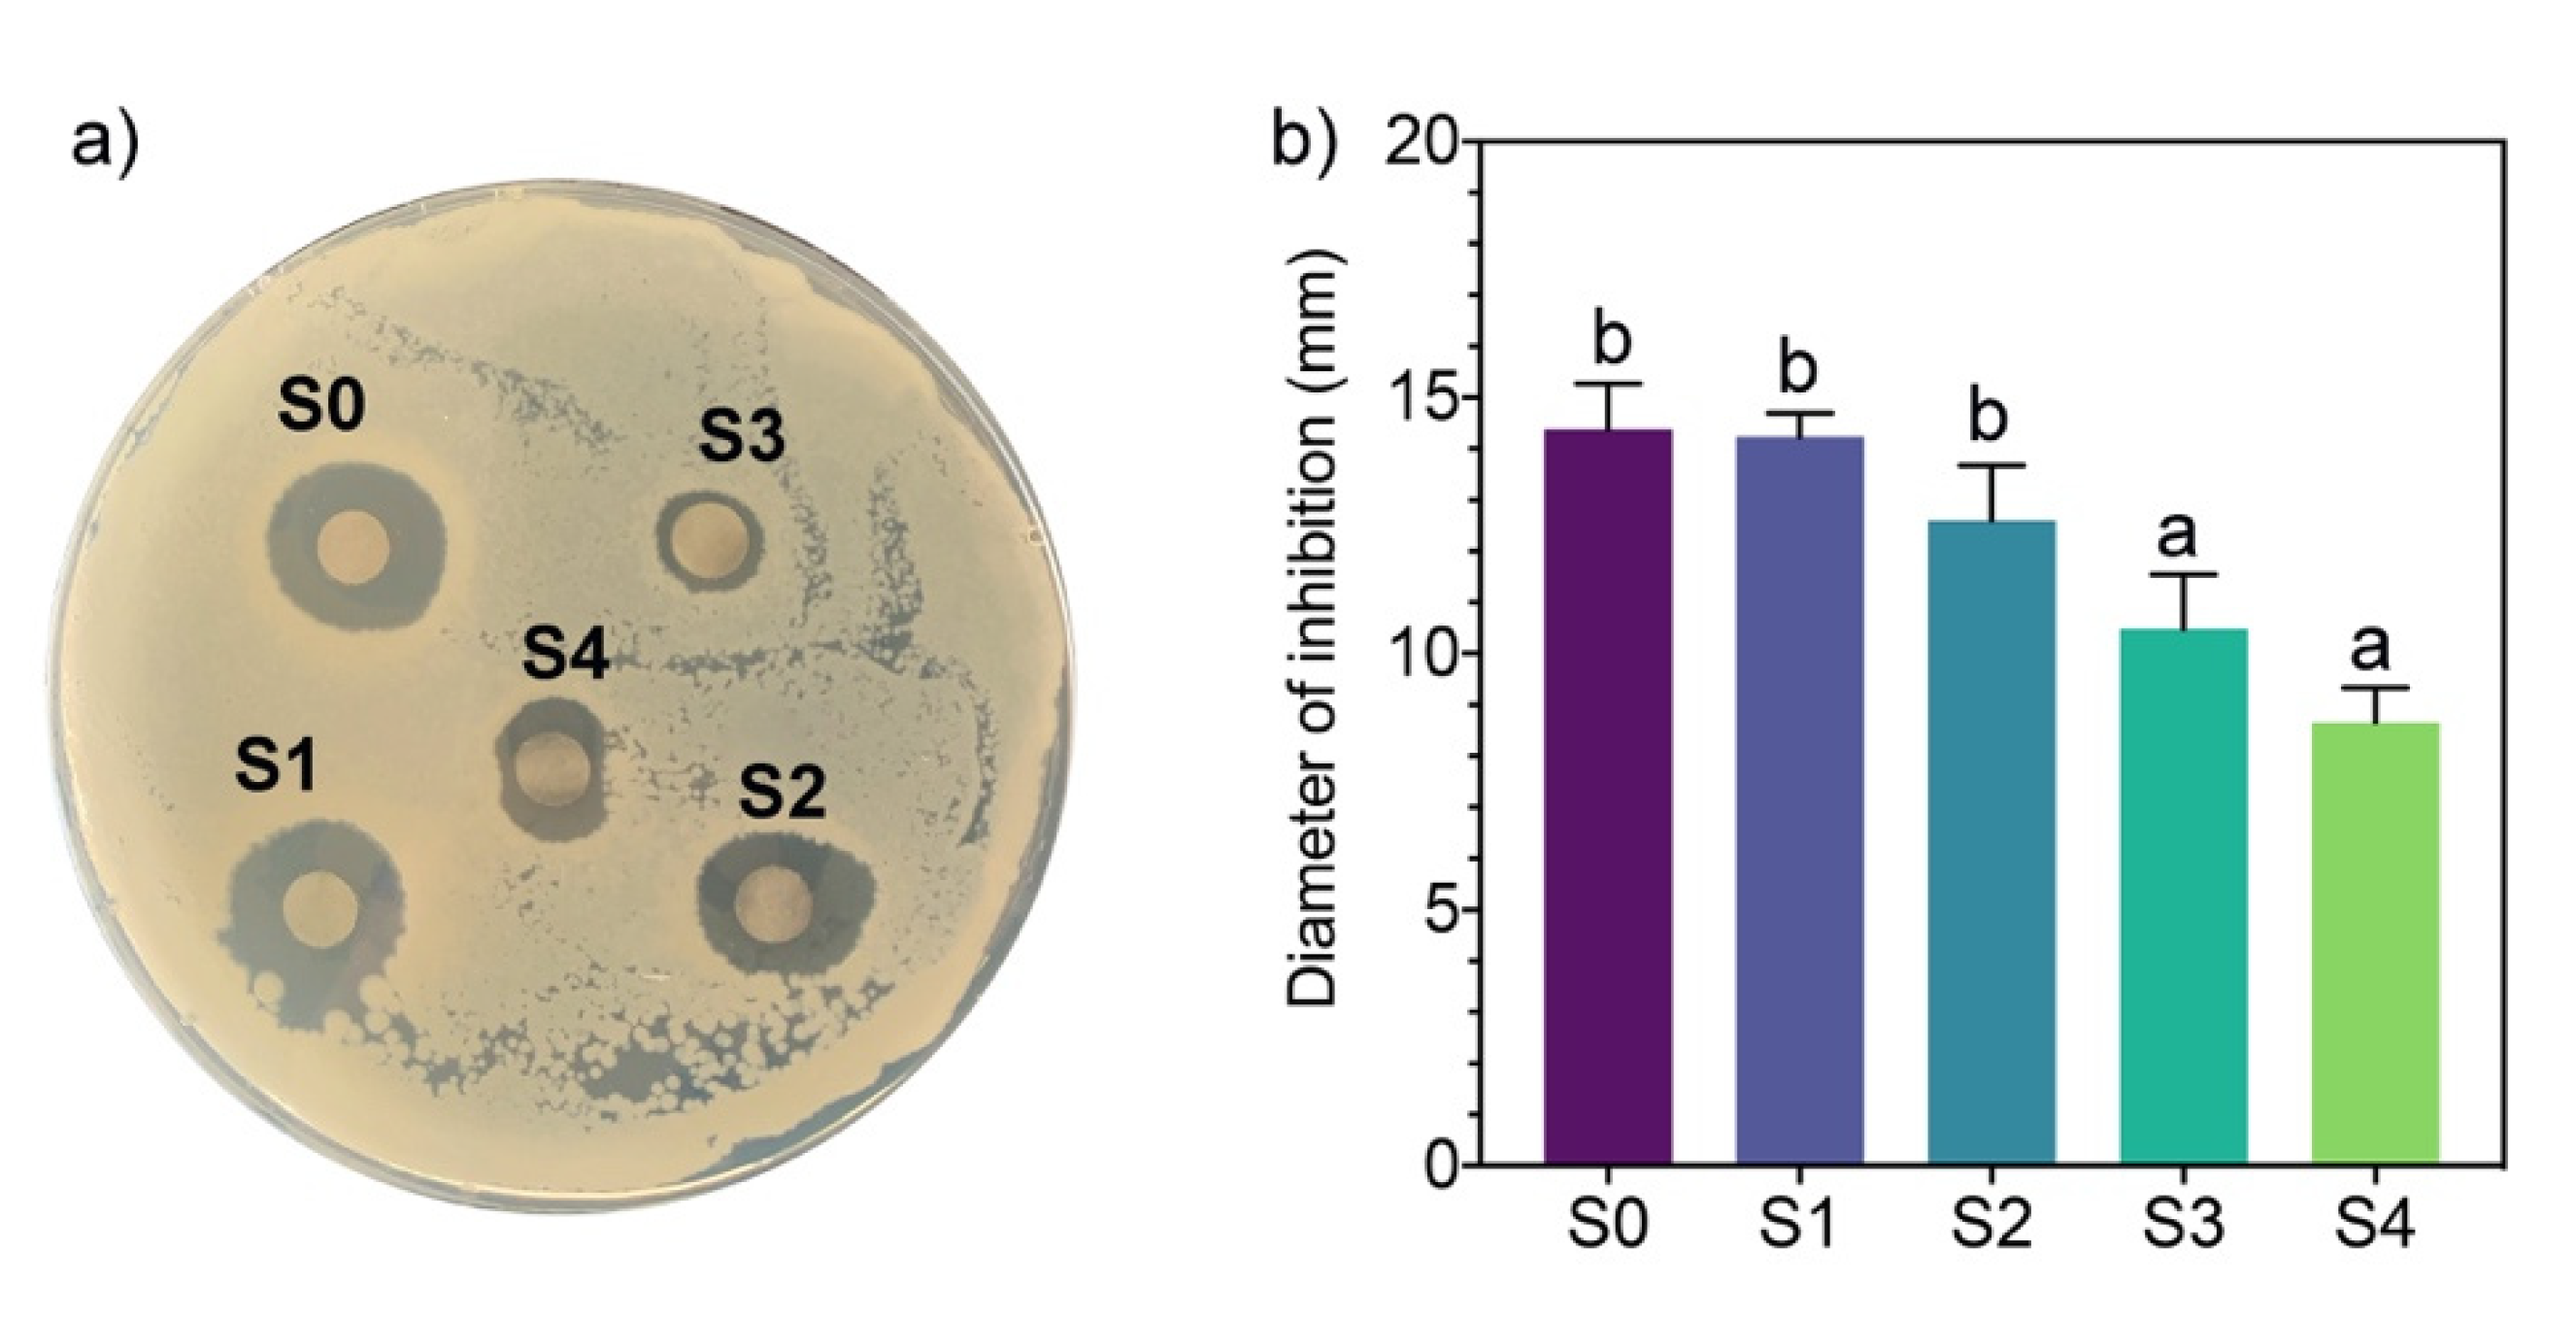
Antibiotics 11 00622 g004

Molecular Weight Identification of Compounds Involved in the Fungal Synthesis of AgNPs: Effect on Antimicrobial and Photocatalytic Activity
Abstract
:1. Introduction
2. Results and Discussion
2.1. SDS-PAGE Electrophoresis of the Mycelia-Free Extract of Stereum hirtusum
2.2. X-ray Diffraction (XRD) Analysis of the Synthesized AgNPs
2.3. UV-Vis Spectroscopy of AgNPs
2.4. Particle Size and Zeta Potential
2.5. Antimicrobial Activity
2.6. Photocatalytic Discoloration of Synthetic Dyes
2.7. Molecular Weight of the Compounds Involved in the AgNPs Synthesis
3. Materials and Methods
3.1. Culture of Microorganisms
3.2. Preparation and Fractionation of the Mycelia-Free Aqueous Extract
3.3. Synthesis of AgNPs
3.4. Characterization of AgNPs
3.5. Antimicrobial Activity of AgNPs
3.6. Photocatalytic Dye Discoloration Using AgNPs
3.7. The SDS-PAGE Electrophoresis of Mycelia-Free Extract
3.8. XRD Analysis of AgNPs
4. Conclusions
Supplementary Materials
Author Contributions
Funding
Institutional Review Board Statement
Informed Consent Statement
Data Availability Statement
Conflicts of Interest
References
- Gudikandula, K.; Vadapally, P.; Singara Charya, M.A. Biogenic Synthesis of Silver Nanoparticles from White Rot Fungi: Their Characterization and Antibacterial Studies. OpenNano 2017, 2, 64–78. [Google Scholar] [CrossRef]
- Zhang, X.F.; Liu, Z.G.; Shen, W.; Gurunathan, S. Silver Nanoparticles: Synthesis, Characterization, Properties, Applications, and Therapeutic Approaches. Int. J. Mol. Sci. 2016, 17, 1534. [Google Scholar] [CrossRef] [PubMed]
- Cuevas, R.; Durán, N.; Diez, M.C.; Tortella, G.R.; Rubilar, O. Extracellular Biosynthesis of Copper and Copper Oxide Nanoparticles by Stereum Hirsutum, a Native White-Rot Fungus from Chilean Forests. J. Nanomater. 2015, 2015, 789089. [Google Scholar] [CrossRef] [Green Version]
- Patel, P.; Agarwal, P.; Kanawaria, S.; Kachhwaha, S.; Kothari, S.L. Plant-Based Synthesis of Silver Nanoparticles and Their Characterization. In Nanotechnology and Plant Sciences: Nanoparticles and Their Impact on Plants; Springer International Publishing: Cham, Switzerland, 2015; pp. 271–288. ISBN 9783319145020. [Google Scholar]
- Shah, M.; Fawcett, D.; Sharma, S.; Tripathy, S.K.; Poinern, G.E.J. Green Synthesis of Metallic Nanoparticles via Biological Entities. Materials 2015, 8, 7278–7308. [Google Scholar] [CrossRef] [Green Version]
- Guilger-Casagrande, M.; Germano-Costa, T.; Bilesky-José, N.; Pasquoto-Stigliani, T.; Carvalho, L.; Fraceto, L.F.; de Lima, R. Influence of the Capping of Biogenic Silver Nanoparticles on Their Toxicity and Mechanism of Action towards Sclerotinia Sclerotiorum. J. Nanobiotechnol. 2021, 19, 53. [Google Scholar] [CrossRef]
- Osorio-Echavarría, J.; Osorio-Echavarría, J.; Ossa-Orozco, C.P.; Gómez-Vanegas, N.A. Synthesis of Silver Nanoparticles Using White-Rot Fungus Anamorphous Bjerkandera Sp. R1: Influence of Silver Nitrate Concentration and Fungus Growth Time. Sci. Rep. 2021, 11, 3842. [Google Scholar] [CrossRef]
- Elgorban, A.M.; Aref, S.M.; Seham, S.M.; Elhindi, K.M.; Bahkali, A.H.; Sayed, S.R.; Manal, M.A. Extracellular Synthesis of Silver Nanoparticles Using Aspergillus versicolor and Evaluation of Their Activity on Plant Pathogenic Fungi. Mycosphere 2016, 7, 844–852. [Google Scholar] [CrossRef]
- Ovais, M.; Khalil, A.T.; Ayaz, M.; Ahmad, I.; Nethi, S.K.; Mukherjee, S. Biosynthesis of Metal Nanoparticles via Microbial Enzymes: A Mechanistic Approach. Int. J. Mol. Sci. 2018, 19, 4100. [Google Scholar] [CrossRef] [Green Version]
- Chowdhury, S.; Basu, A.; Kundu, S. Green Synthesis of Protein Capped Silver Nanoparticles from Phytopathogenic Fungus Macrophomina phaseolina (Tassi) Goid with Antimicrobial Properties against Multidrug-Resistant Bacteria. Nanoscale Res. Lett. 2014, 9, 365. [Google Scholar] [CrossRef] [Green Version]
- Li, G.; He, D.; Qian, Y.; Guan, B.; Gao, S.; Cui, Y.; Yokoyama, K.; Wang, L. Fungus-Mediated Green Synthesis of Silver Nanoparticles Using Aspergillus terreus. Int. J. Mol. Sci. 2012, 13, 466–476. [Google Scholar] [CrossRef] [Green Version]
- Hietzschold, S.; Walter, A.; Davis, C.; Taylor, A.A.; Sepunaru, L. Does Nitrate Reductase Play a Role in Silver Nanoparticle Synthesis? Evidence for NADPH as the Sole Reducing Agent. ACS Sustain. Chem. Eng. 2019, 7, 8070–8076. [Google Scholar] [CrossRef]
- Roy, A.; Bulut, O.; Some, S.; Mandal, A.K.; Yilmaz, M.D. Green Synthesis of Silver Nanoparticles: Biomolecule-Nanoparticle Organizations Targeting Antimicrobial Activity. RSC Adv. 2019, 9, 2673–2702. [Google Scholar] [CrossRef] [Green Version]
- Rodrigues, A.G.; Ping, L.Y.; Marcato, P.D.; Alves, O.L.; Silva, M.C.P.; Ruiz, R.C.; Melo, I.S.; Tasic, L.; de Souza, A.O. Biogenic Antimicrobial Silver Nanoparticles Produced by Fungi. Appl. Microbiol. Biotechnol. 2013, 97, 775–782. [Google Scholar] [CrossRef]
- Guilger-Casagrande, M.; Lima, R. de Synthesis of Silver Nanoparticles Mediated by Fungi: A Review. Front. Bioeng. Biotechnol. 2019, 7, 287. [Google Scholar] [CrossRef] [Green Version]
- Kora, A.J.; Rastogi, L. Enhancement of Antibacterial Activity of Capped Silver Nanoparticles in Combination with Antibiotics, on Model Gram-Negative and Gram-Positive Bacteria. Bioinorg. Chem. Appl. 2013, 2013, 871097. [Google Scholar] [CrossRef]
- Gola, D.; Kriti, A.; Bhatt, N.; Bajpai, M.; Singh, A.; Arya, A.; Chauhan, N.; Srivastava, S.K.; Tyagi, P.K.; Agrawal, Y. Silver Nanoparticles for Enhanced Dye Degradation. Curr. Res. Green Sustain. Chem. 2021, 4, 100132. [Google Scholar] [CrossRef]
- Sumi, M.B.; Devadiga, A.; Shetty, K.V.; Saidutta, M.B. Solar Photocatalytically Active, Engineered Silver Nanoparticle Synthesis Using Aqueous Extract of Mesocarp of Cocos Nucifera (Red Spicata Dwarf). J. Exp. Nanosci. 2017, 12, 14–32. [Google Scholar] [CrossRef] [Green Version]
- Vanaja, M.; Paulkumar, K.; Baburaja, M.; Rajeshkumar, S.; Gnanajobitha, G.; Malarkodi, C.; Sivakavinesan, M.; Annadurai, G. Degradation of Methylene Blue Using Biologically Synthesized Silver Nanoparticles. Bioinorg. Chem. Appl. 2014, 2014, 742346. [Google Scholar] [CrossRef]
- Javed, R.; Zia, M.; Naz, S.; Aisida, S.O.; ul Ain, N.; Ao, Q. Role of Capping Agents in the Application of Nanoparticles in Biomedicine and Environmental Remediation: Recent Trends and Future Prospects. J. Nanobiotechnol. 2020, 18, 172. [Google Scholar] [CrossRef] [PubMed]
- Sun, Q.; Cai, X.; Li, J.; Zheng, M.; Chen, Z.; Yu, C.-P. Green Synthesis of Silver Nanoparticles Using Tea Leaf Extract and Evaluation of Their Stability and Antibacterial Activity. Colloids Surf. A Physicochem. Eng. Asp. 2014, 444, 226–231. [Google Scholar] [CrossRef]
- Anandalakshmi, K.; Venugobal, J.; Ramasamy, V. Characterization of Silver Nanoparticles by Green Synthesis Method Using Pedalium Murex Leaf Extract and Their Antibacterial Activity. Appl. Nanosci. 2016, 6, 399–408. [Google Scholar] [CrossRef] [Green Version]
- Mistry, H.; Thakor, R.; Patil, C.; Trivedi, J.; Bariya, H. Biogenically Proficient Synthesis and Characterization of Silver Nanoparticles Employing Marine Procured Fungi Aspergillus brunneoviolaceus along with Their Antibacterial and Antioxidative Potency. Biotechnol. Lett. 2021, 43, 307–316. [Google Scholar] [CrossRef] [PubMed]
- Cisternas, C.; Tortella, G.; Seabra, A.B.; Pieretti, J.C.; Araya-Castro, K.; Hermosilla, E.; Cristina Diez, M.; Rubilar, O. Development of a New Biomimetic Method for the Synthesis of Silver Nanoparticles Based on Fungal Metabolites: Optimization and Antibacterial Activity. J. Chem. Technol. Biotechnol. 2021, 96, 1981–1990. [Google Scholar] [CrossRef]
- Fernández-Ponce, C.; Muñoz-Miranda, J.P.; de los Santos, D.M.; Aguado, E.; García-Cozar, F.; Litrán, R. Influence of Size and Surface Capping on Photoluminescence and Cytotoxicity of Gold Nanoparticles. J. Nanopart. Res. 2018, 20, 305. [Google Scholar] [CrossRef] [Green Version]
- Erdogan, O.; Abbak, M.; Demirbolat, G.M.; Birtekocak, F.; Aksel, M.; Pasa, S.; Cevik, O. Green Synthesis of Silver Nanoparticles via Cynara Scolymus Leaf Extracts: The Characterization, Anticancer Potential with Photodynamic Therapy in MCF7 Cells. PLoS ONE 2019, 14, e0216496. [Google Scholar] [CrossRef] [Green Version]
- Shahryari, F.; Rabiei, Z.; Sadighian, S. Antibacterial Activity of Synthesized Silver Nanoparticles by Sumac Aqueous Extract and Silver-Chitosan Nanocomposite against Pseudomonas Syringae Pv. Syringae. J. Plant Pathol. 2020, 102, 469–475. [Google Scholar] [CrossRef]
- Jaffri, S.B.; Ahmad, K.S. Augmented Photocatalytic, Antibacterial and Antifungal Activity of Prunosynthetic Silver Nanoparticles. Artif. Cells Nanomed. Biotechnol. 2018, 46, 127–137. [Google Scholar] [CrossRef] [Green Version]
- Mohanta, Y.K.; Singdevsachan, S.K.; Parida, U.K.; Panda, S.K.; Mohanta, T.K.; Bae, H. Green Synthesis and Antimicrobial Activity of Silver Nanoparticles Using Wild Medicinal Mushroom Ganoderma Applanatum (Pers.) Pat. from Similipal Biosphere Reserve, Odisha, India. IET Nanobiotechnol. 2016, 10, 184–189. [Google Scholar] [CrossRef] [PubMed]
- Tortella, G.; Rubilar, O.; Fincheira, P.; Pieretti, J.C.; Duran, P.; Lourenço, I.M.; Seabra, A.B.; Fernanda, M.; Carvalho, N.N. Antibiotics Bactericidal and Virucidal Activities of Biogenic Metal-Based Nanoparticles: Advances and Perspectives. Antibiotics 2021, 10, 783. [Google Scholar] [CrossRef] [PubMed]
- Yin, I.X.; Zhang, J.; Zhao, I.S.; Mei, M.L.; Li, Q.; Chu, C.H. The Antibacterial Mechanism of Silver Nanoparticles and Its Application in Dentistry. Int. J. Nanomed. 2020, 15, 2555–2562. [Google Scholar] [CrossRef] [PubMed] [Green Version]
- Suvith, V.S.; Philip, D. Catalytic Degradation of Methylene Blue Using Biosynthesized Gold and Silver Nanoparticles. Spectrochim. Acta—Part A Mol. Biomol. Spectrosc. 2014, 118, 526–532. [Google Scholar] [CrossRef]
- Dincer, I.; Zamfirescu, C. Hydrogen Production by Photonic Energy. In Sustainable Hydrogen Production; Elsevier: New York, NY, USA, 2016; pp. 309–391. [Google Scholar]
- Chen, X.; Zheng, Z.; Ke, X.; Jaatinen, E.; Xie, T.; Wang, D.; Guo, C.; Zhao, J.; Zhu, H. Supported Silver Nanoparticles as Photocatalysts under Ultraviolet and Visible Light Irradiation. Green Chem. 2010, 12, 414–441. [Google Scholar] [CrossRef]
- Clark, M. Handbook of Textile and Industrial Dyeing. Volume 2, Applications of Dyes; Woodhead Publishing: Sawston, UK, 2011; ISBN 9781845696962. [Google Scholar]
- Jain, N.; Bhargava, A.; Majumdar, S.; Tarafdar, J.C.; Panwar, J. Extracellular Biosynthesis and Characterization of Silver Nanoparticles Using Aspergillus flavus NJP08: A Mechanism Perspective. Nanoscale 2011, 3, 635–641. [Google Scholar] [CrossRef]
- Laemmli, U.K. Cleavage of Structural Proteins during the Assembly of the Head of Bacteriophage T4. Nature 1970, 227, 680–685. [Google Scholar] [CrossRef]

| Parameter | Synthesis Fraction | ||||
|---|---|---|---|---|---|
| S0 | S1 | S2 | S3 | S4 | |
| SPR peak (nm) | 417 | 421 | 403 | 414 | 403 |
| Particle size DLS (nm) | 79.3 ± 30.6b | 66.0 ± 10.2b | 19.1 ± 4.1a | 17.0 ± 5.0a | 14.3 ± 2.0a |
| Zeta potential (mV) | −33.1 ± 2.4b | −40.0 ± 10.4ab | −44.8 ± 8.4a | −38.8 ± 4.2ab | −44.1 ± 2.9a |
| TEM size (nm) | 13.80 ± 4.13c | 9.06 ± 4.16a | 10.47 ± 3.53ab | 22.48 ± 3.46d | 16.92 ± 5.77c |
| Direct gap band (eV) | 2.61 | 2.62 | 2.76 | 2.76 | 2.67 |
| Synthetic Dye | λmax (nm) | Concentration (μM) |
|---|---|---|
| Acid blue 1 | 610 | 20 |
| Acid orange 6 | 590 | 20 |
| Acid red 27 | 525 | 40 |
| Basic blue 24 | 590 | 20 |
| Basic blue 3 | 650 | 20 |
| Basic blue 41 | 610 | 20 |
| Basic orange 2 | 450 | 25 |
| Basic violet 4 | 596 | 20 |
| Reactive blue 19 | 600 | 50 |
| Reactive blue 5 | 600 | 32 |
Publisher’s Note: MDPI stays neutral with regard to jurisdictional claims in published maps and institutional affiliations. |
© 2022 by the authors. Licensee MDPI, Basel, Switzerland. This article is an open access article distributed under the terms and conditions of the Creative Commons Attribution (CC BY) license (https://creativecommons.org/licenses/by/4.0/).
Share and Cite
Hermosilla, E.; Díaz, M.; Vera, J.; Seabra, A.B.; Tortella, G.; Parada, J.; Rubilar, O. Molecular Weight Identification of Compounds Involved in the Fungal Synthesis of AgNPs: Effect on Antimicrobial and Photocatalytic Activity. Antibiotics 2022, 11, 622. https://doi.org/10.3390/antibiotics11050622
Hermosilla E, Díaz M, Vera J, Seabra AB, Tortella G, Parada J, Rubilar O. Molecular Weight Identification of Compounds Involved in the Fungal Synthesis of AgNPs: Effect on Antimicrobial and Photocatalytic Activity. Antibiotics. 2022; 11(5):622. https://doi.org/10.3390/antibiotics11050622
Chicago/Turabian StyleHermosilla, Edward, Marcela Díaz, Joelis Vera, Amedea B. Seabra, Gonzalo Tortella, Javiera Parada, and Olga Rubilar. 2022. "Molecular Weight Identification of Compounds Involved in the Fungal Synthesis of AgNPs: Effect on Antimicrobial and Photocatalytic Activity" Antibiotics 11, no. 5: 622. https://doi.org/10.3390/antibiotics11050622
APA StyleHermosilla, E., Díaz, M., Vera, J., Seabra, A. B., Tortella, G., Parada, J., & Rubilar, O. (2022). Molecular Weight Identification of Compounds Involved in the Fungal Synthesis of AgNPs: Effect on Antimicrobial and Photocatalytic Activity. Antibiotics, 11(5), 622. https://doi.org/10.3390/antibiotics11050622

